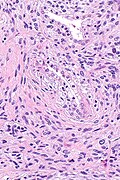

Prostatic stromal sarcoma
Jump to navigation
Jump to search
Prostatic stromal sarcoma, abbreviated PSS, is a very rare malignant tumour that arises from the stroma of the prostate gland.
General
- Very rare - case reports.
Microscopic
Features:
- Atypical spindle cells.
- Necrosis or increased mitotic activity.[1]
DDx:
- Prostatic stromal tumour of uncertain malignant potential (STUMP).
- Gastrointestinal stromal tumour.[2]
- Other sarcomas.
- Carcinosarcoma of the prostate.[3]
- Radiation changes.
- Sarcomatoid prostate carcinoma - classically has conventional prostate carcinoma, frequently postradiation treatment.
Images
www
See also
References
- ↑ De Berardinis, E.; Busetto, GM.; Antonini, G.; Giovannone, R.; Di Placido, M.; Magliocca, FM.; Di Silverio, A.; Gentile, V. (2012). "Incidental prostatic stromal tumor of uncertain malignant potential (STUMP): histopathological and immunohistochemical findings.". Urologia 79 (1): 65-8. doi:10.5301/RU.2012.9099. PMID 22388992.
- ↑ de la Roza G, Naqvi A, Clark K (February 2009). "Gastrointestinal stromal tumors presenting as a prostatic mass". Can J Urol 16 (1): 4502–6. PMID 19222892.
- ↑ 3.0 3.1 3.2 Hansel, DE.; Herawi, M.; Montgomery, E.; Epstein, JI. (Jan 2007). "Spindle cell lesions of the adult prostate.". Mod Pathol 20 (1): 148-58. doi:10.1038/modpathol.3800676. PMID 17170745.